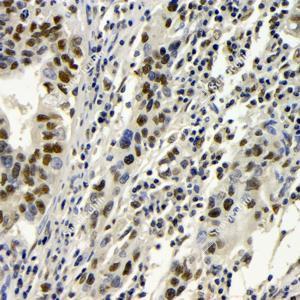
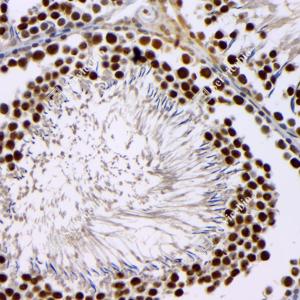

Anti-BRCA1 Rabbit pAb
- 100 μL
产品信息
|
蛋白质全称 |
乳腺癌易感蛋白1同源物 |
|
别名 |
BRCA1, BRCAI, BRCC1, breast cancer 1, early onset, BROVCA1, IRIS, PSCP, RING finger protein 53, RNF53 |
|
Uniprot ID |
P48754 |
|
免疫原 |
KLH偶联的小鼠BRCA1合成肽 |
|
抗体亚型 |
IgG |
|
纯化方式 |
亲和纯化 |
|
亚细胞定位 |
细胞核, 染色体, 细胞质 |
应用
| 应用 | 物种 | 稀释 | 阳性样品 |
| IHC/IF 免疫组织化学/免疫荧光 | 人, 小鼠, 大鼠 | 1: 100-1: 300 | 结肠, 心, 肺, 睾丸, 胰腺 |
背景
E3 ubiquitin-protein ligase that specifically mediates the formation of 'Lys-6'-linked polyubiquitin chains and plays a central role in DNA repair by facilitating cellular responses to DNA damage. It is unclear whether it also mediates the formation of other types of polyubiquitin chains. The BRCA1-BARD1 heterodimer coordinates a diverse range of cellular pathways such as DNA damage repair, ubiquitination and transcriptional regulation to maintain genomic stability. Regulates centrosomal microtubule nucleation. Required for appropriate cell cycle arrests after ionizing irradiation in both the S-phase and the G2 phase of the cell cycle.
图像
|
|
IHC检测BRCA1蛋白(货号 GB115539). 样品: 人结肠, 4%多聚甲醛 (货号G1101) 固定12-24小时. 抗原修复: Tris-EDTA抗原修复液(pH 9.0) (G1203), 98℃, 20分钟. —抗: 1: 100稀释, 4℃ 孵育过夜. 二抗: HRP标记山羊抗兔IgG (H+L) (货号GB23303), 1: 200稀释, 室温孵育1小时. |
|
|
IHC检测BRCA1蛋白(货号 GB115539). 样品: 人胃癌, 4%多聚甲醛 (货号G1101) 固定12-24小时. 抗原修复: Tris-EDTA抗原修复液(pH 9.0) (G1203), 98℃, 20分钟. —抗: 1: 100稀释, 4℃ 孵育过夜. 二抗: HRP标记山羊抗兔IgG (H+L) (货号GB23303), 1: 200稀释, 室温孵育1小时. |
|
|
IHC检测BRCA1蛋白(货号 GB115539). 样品: 人结肠癌, 4%多聚甲醛 (货号G1101) 固定12-24小时. 抗原修复: Tris-EDTA抗原修复液(pH 9.0) (G1203), 98℃, 20分钟. —抗: 1: 100稀释, 4℃ 孵育过夜. 二抗: HRP标记山羊抗兔IgG (H+L) (货号GB23303), 1: 200稀释, 室温孵育1小时. |
|
|
IHC检测BRCA1蛋白(货号 GB115539). 样品: 小鼠心, 4%多聚甲醛 (货号G1101) 固定12-24小时. 抗原修复: Tris-EDTA抗原修复液(pH 9.0) (G1203), 98℃, 20分钟. —抗: 1: 100稀释, 4℃ 孵育过夜. 二抗: HRP标记山羊抗兔IgG (H+L) (货号GB23303), 1: 200稀释, 室温孵育1小时. |
|
|
IHC检测BRCA1蛋白(货号 GB115539). 样品: 大鼠睾丸, 4%多聚甲醛 (货号G1101) 固定12-24小时. 抗原修复: Tris-EDTA抗原修复液(pH 9.0) (G1203), 98℃, 20分钟. —抗: 1: 100稀释, 4℃ 孵育过夜. 二抗: HRP标记山羊抗兔IgG (H+L) (货号GB23303), 1: 200稀释, 室温孵育1小时. |
|
|
IHC检测BRCA1蛋白(货号 GB115539). 样品: 小鼠睾丸, 4%多聚甲醛 (货号G1101) 固定12-24小时. 抗原修复: Tris-EDTA抗原修复液(pH 9.0) (G1203), 98℃, 20分钟. —抗: 1: 100稀释, 4℃ 孵育过夜. 二抗: HRP标记山羊抗兔IgG (H+L) (货号GB23303), 1: 200稀释, 室温孵育1小时. |
储存
| 储存条件 | 在-20℃下储存一年, 避免反复冻融. |
| 储存缓冲液 | 含0.15% ProClin300防腐剂, 100 μg/mL牛血清白蛋白和50%甘油的磷酸盐缓冲液. |
注意:
1.本产品仅供研究使用.
2.建议用一抗稀释液(G2025)稀释本产品.
| 货号 | 名称 | 规格 | 价格 | 操作 |
|---|
| 货号 | 名称 | 规格 | 价格 | 操作 |
|---|